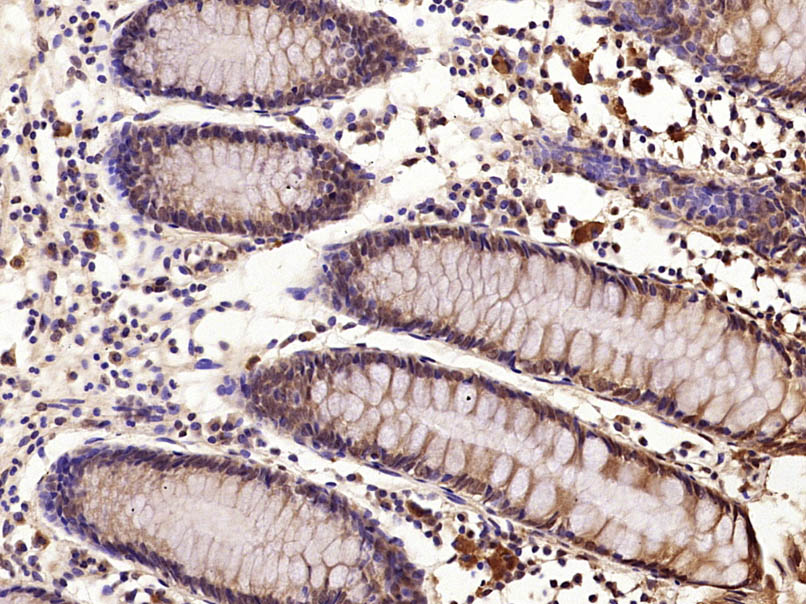
产品细节图片7

相关产品推荐更多 >

SLC27A5 Rabbit pAb(bs-4088R)-50ul/100ul/200ul
¥1180
MAML1 Rabbit pAb(bs-12396R)-50ul/100ul/200ul
¥1180
Cyclin E1 Rabbit pAb, PerCP conjugated(bs-0573R-PerCP)-100ul
¥2980
MDR1/P Glycoprotein Rabbit pAb, APC-Cy7 conjugated(bs-1468R-APC-Cy7)-100ul
¥2980
SMAD5 Rabbit pAb, APC conjugated(bs-13890R-APC)-100ul
¥2980
万千商家帮你免费找货
0 人在求购买到急需产品
- 详细信息
- 文献和实验
- 技术资料
- 应用范围:
产品信息以Bioss网站为准
- 规格:
50ul/100ul/200ul
| 规格: | 50ul | 产品价格: | ¥1180.0 |
|---|---|---|---|
| 规格: | 100ul | 产品价格: | ¥1980.0 |
| 规格: | 200ul | 产品价格: | ¥2800.0 |
| 产品编号 | bs-4076R |
| 英文名称 | phospho-E2F1 (Ser364) Rabbit pAb |
| 中文名称 | 磷酸化转录因子E2F-1抗体 |
| 英文别名 | E2F1(phospho S364); E2F1(phospho Ser364); p-E2F1(S364); p-E2F1(Ser364); E2F 1; E2F transcription factor 1; E2F-1; E2f1 E2F transcription factor 1; KIAA4009; mKIAA4009; OTTHUMP00000030661; PBR 3; PBR3; PRB binding protein E2F 1; PRB-binding protein E2F-1; RBAP 1; RBAP-1; RBAP1; RBBP 3; RBBP-3; RBBP3; RBP 3; RBP3; Retinoblastoma associated protein 1; Retinoblastoma binding protein 3; Retinoblastoma-associated protein 1; Retinoblastoma-binding protein 3; Transcription factor E2F1; E2F1_HUMAN. |
| 产品应用 | WB=1:500-2000, IHC-P=1:100-500, IHC-F=1:100-500, ICC/IF=1:100-500, IF=1:100-500, Flow-Cyt=1ug/Test Not yet tested in other applications. |
| 交叉反应 | Human, Rat (Mouse) |
| 抗体来源 | Rabbit |
| 免疫原 | KLH conjugated Synthesised phosphopeptide derived from human E2F1 around the phosphorylation site of Ser364 |
| 亚型 | IgG |
| 性状 | Liquid |
| 纯化方法 | affinity purified by Protein A |
| 克隆类型 | Polyclonal |
| 理论分子量 | 48 kDa |
| 浓度 | 1mg/ml |
| 储存液 | 0.01M TBS (pH7.4) with 1% BSA, 0.02% Proclin300 and 50% Glycerol. |
| 研究领域 | Cancer > Oncoproteins/suppressors > Tumor suppressors > Rb family Epigenetics and Nuclear Signaling > Transcription > Domain Families > Forkhead Box Epigenetics and Nuclear Signaling > Transcription > Other factors |
| 亚基 | Component of the DRTF1/E2F transcription factor complex. Forms heterodimers with DP family members. The E2F-1 complex binds specifically hypophosphorylated retinoblastoma protein RB1. During the cell cycle, RB1 becomes phosphorylated in mid-to-late G1 phase, detaches from the DRTF1/E2F complex, rendering E2F transcriptionally active. Viral oncoproteins, notably E1A, T-antigen and HPV E7, are capable of sequestering RB protein, thus releasing the active complex. Interacts with TRRAP, which probably mediates its interaction with histone acetyltransferase complexes, leading to transcription activation. Binds TOPBP1 and EAPP. Interacts with ARID3A. Interacts with TRIM28; the interaction inhibits E2F1 acetylation through recruiting HDAC1 and represses its transcriptional activity. Interaction with KAT2B; the interaction acetylates E2F1 enhancing its DNA-binding and transcriptional activity. Interacts with BIRC2/c-IAP1 (via BIR domains). Interacts with human cytomegalovirus/HHV-5 protein UL123. |
| 亚细胞定位 | Nucleus. |
| 翻译后修饰 | Phosphorylated by CDK2 and cyclin A-CDK2 in the S-phase. |
| 相似性 | Belongs to the E2F/DP family. |
| 功能 | Transcription activator that binds DNA cooperatively with dp proteins through the E2 recognition site, 5'-TTTC[CG]CGC-3' found in the promoter region of a number of genes whose products are involved in cell cycle regulation or in DNA replication. The DRTF1/E2F complex functions in the control of cell-cycle progression from G1 to S phase. E2F-1 binds preferentially RB1 protein, in a cell-cycle dependent manner. It can mediate both cell proliferation and p53-dependent apoptosis. |
| 保存条件 | Shipped at 4℃. Store at -20℃ for one year. Avoid repeated freeze/thaw cycles. |
| 注意事项 | This product as supplied is intended for research use only, not for use in human, therapeutic or diagnostic applications. |
| 背景资料 | E2F's are DNA binding proteins, which associate with negative regulators, such as the retinoblastoma p107 protein, resulting in an altered rate of gene transcription. The E2F proteins contain several evolutionally conserved domains found in most members of the family. These domains include a DNA binding domain, a dimerization domain which determines interaction with the differentiation regulated transcription factor proteins (DP), a transactivation domain enriched in acidic amino acids, and a tumor suppressor protein association domain which is embedded within the transactivation domain. This protein and another 2 members, E2F2 and E2F3, have an additional cyclin binding domain. E2F1 is proposed to be involved in several cellular processes that range from tumor suppressor, cell progression and oncogenesis. E2F1 overexpression can also drive cells into apoptosis. |
| 应用 | 推荐稀释比例 |
| {WB} | {1:500-2000} |
| {IHC-P} | {1:100-500} |
| {IHC-F} | {1:100-500} |
| {ICC/IF} | {1:100-500} |
| {IF} | {1:100-500} |
| {Flow-Cyt} | {1ug/Test} |




Primary Antibody (green line): Rabbit Anti-phospho-E2F1 (Ser364) antibody (bs-4076R)
Dilution: 1μg /10^6 cells;
Isotype Control Antibody (orange line): Rabbit IgG .
Secondary Antibody (white blue line): Goat anti-rabbit IgG-AF647
Dilution: 1μg /test.
Protocol
The cells were fixed with 4% PFA (10min at room temperature)and then permeabilized with 90% ice-cold methanol for 20 min at room temperature. The cells were then incubated in 5%BSA to block non-specific protein-protein interactions for 30 min at room temperature .Cells stained with Primary Antibody for 30 min at room temperature. The secondary antibody used for 40 min at room temperature. Acquisition of 20,000 events was performed.

Primary Antibody (green line): Rabbit Anti-phospho-E2F1 (Ser364) antibody (bs-4076R)
Dilution: 1ug/Test;
Secondary Antibody : Goat anti-rabbit IgG-FITC
Dilution: 0.5ug/Test.
Protocol
The cells were fixed with 4% PFA (10min at room temperature)and then permeabilized with 0.1% PBST for 20 min at room temperature.The cells were then incubated in 5%BSA to block non-specific protein-protein interactions for 30 min at room temperature .Cells stained with Primary Antibody for 30 min at room temperature. The secondary antibody used for 40 min at room temperature. Acquisition of 20,000 events was performed.

Lane 1: Hela (Human) Cell Lysate at 30 ug
Lane 2: A673 (Human) Cell Lysate at 30 ug
Lane 3: Molt-4 (Human) Cell Lysate at 30 ug
Primary: Anti-phospho-E2F1 (Ser364) (bs-4076R) at 1/1000 dilution
Secondary: IRDye800CW Goat Anti-Rabbit IgG at 1/20000 dilution
Predicted band size: 55-60 kD
Observed band size: 60 kD
风险提示:丁香通仅作为第三方平台,为商家信息发布提供平台空间。用户咨询产品时请注意保护个人信息及财产安全,合理判断,谨慎选购商品,商家和用户对交易行为负责。对于医疗器械类产品,请先查证核实企业经营资质和医疗器械产品注册证情况。
文献和实验:使用 Anti-phospho-Akt (Ser473) Rabbit mAb 对石蜡包埋的人乳腺癌组织进行免疫组织化学分析。(图 A)使用免疫组化试剂盒M&R HRP/DAB Detection IHC Kit,抗体 1:100 稀释;(图 B) 采用普通免疫组化试剂盒,抗体 1:25 稀释。 图 6 免疫组化实验检测 Erk1/2 表达 注:使用 Anti-Erk1/2 Mouse mAb与p44/42 MAPK (Erk1/2)Rabbit mAb 对正常小鼠心脏组织进行免疫
at 10, 25, and 50 μM). At 24 h post-treatment, celllysates were obtained; SDS-PAGE and Western blotting were performed as described in Section 3, Methods. AR-A014418dose-dependent decreases of phospho-β-catenin (Ser33/37) and phospho-glycogen synthase
(Ser473)(193H12)Rabbit mAb,1:300,稀释,二抗是驴抗兔,1:2000,我是实验室的新手,刚呆俩月,受 此挫折,一头雾水,请过来人或者有经验的同学帮忙解答怎样解决,非常感谢! 碧峤 pAkt有两个位点,Ser473和Thr308,其中Ser473相对容易显色。如果显色失败,可能的原因:1 上样量过少,我们一般都是30μg;2 一抗孵育时间过短,我们一般24h~48h;3 一抗是否工作有待排除 米宝
技术资料暂无技术资料 索取技术资料





